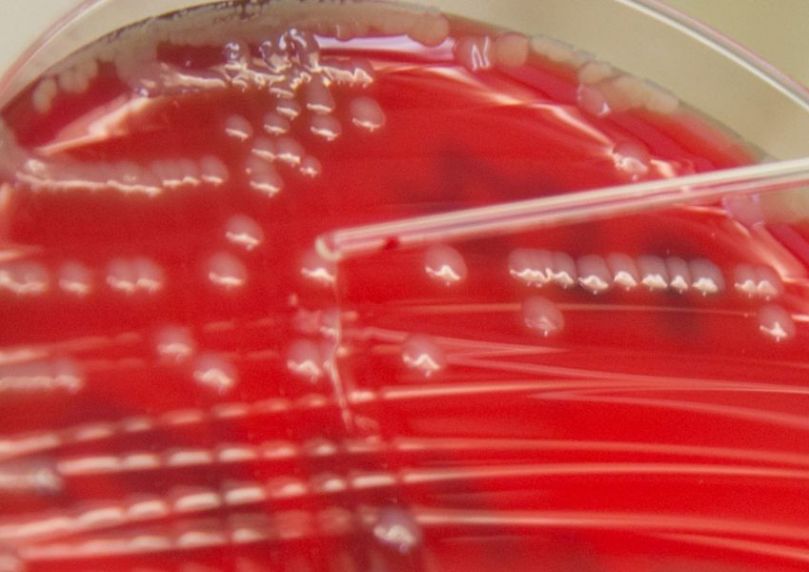
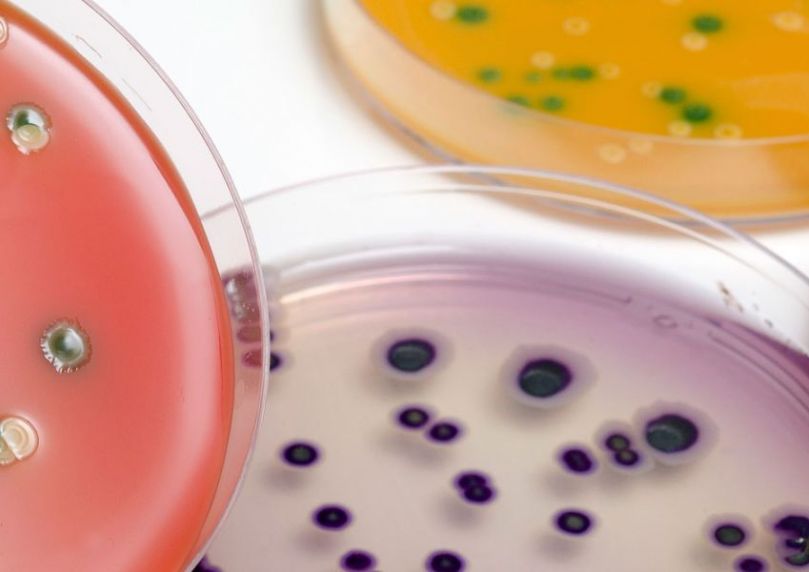

Quick access

Page thématique
Food and nutrition
Food is central to our daily lives. When it is safe and nutritious, it is a powerful ally for our health. However, an imbalanced diet or contaminated food can expose us to immediate risks or chronic diseases. ANSES provides scientific expertise at all stages of the food chain, from the production of foods of animal or plant origin through to the consumer's plate. It assesses the risks associated with the contamination of food by pathogens and toxic substances. It also assesses nutritional quality, and the risks of physical inactivity and sedentary behaviour.
Publications
Date de mise en ligne
Date de mise en ligne
Date de mise en ligne
Numéro de saisine
Date de mise en ligne
Opinion on Updating the State of the Evidence on the Prevention of Neural Tube Defects by vitamin B9
Date de mise en ligne
Numéro de saisine
Date de mise en ligne
Date de mise en ligne
Date de mise en ligne
Numéro de saisine
Date de mise en ligne
Date de mise en ligne
Numéro de saisine
Date de mise en ligne
Numéro de saisine
Date de mise en ligne
Numéro de saisine
Date de mise en ligne
Opinion on Updating the State of the Evidence on the Prevention of Neural Tube Defects by vitamin B9
Date de mise en ligne
Numéro de saisine
Date de mise en ligne
Date de mise en ligne
Numéro de saisine
Date de mise en ligne
Numéro de saisine
Date de mise en ligne
Numéro de saisine
Date de mise en ligne
Date de mise en ligne
Date de mise en ligne
Numéro de saisine
Date de mise en ligne
Date de mise en ligne
Numéro de saisine
Date de mise en ligne
Numéro de saisine
Date de mise en ligne
Numéro de saisine